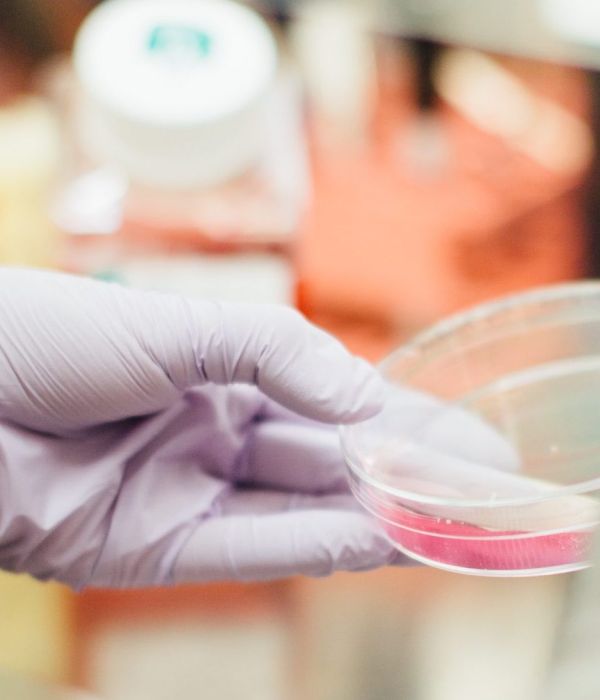
Mosquito

Scientific Publications
One Health approach uncovers emergence and dynamics of Usutu and West Nile viruses in the Netherlands
Emmanuelle Münger, Nnomzie C. Atama, Jurrian van Irsel, Rody Blom, Louie Krol, Tjomme van Mastrigt, Tijs J. van den Berg, Marieta Braks, Ankje de Vries, Anne van der Linden, Irina Chestakova, Marjan Boter, Felicity D. Chandler, Robert Kohl, David F. Nieuwenhuijse, Mathilde Uiterwijk, Ron A. M. Fouchier, Hein Sprong, Andrea Gröne, Constantianus J. M. Koenraadt, Maarten Schrama, Chantal B. E. M. Reusken, Arjan Stroo, Judith M. A. van den Brand, Henk P. van der Jeugd, Bas B. Oude Munnink, Reina S. Sikkema, Marion P.G. Koopmans
Effect of mosquito saliva from distinct species on human dermal endothelial cell function in vitro and West Nile virus pathogenesis in vivo
Imke Visser, Vincent Vaes, Peter van Run, Eleanor M. Marshall, Lars Vermaat, Charlotte Linthout, Dick H.W. Dekkers, Jeroen A.A. Demmers, Marion P.G. Koopmans, Constantianus J.M. Koenraadt, Melanie Rissmann, Barry Rockx
Taylor & Francis – Emerging Microbes & Infections
Attenuating Mutations in Usutu Virus: Towards Understanding Orthoflavivirus Virulence Determinants and Live Attenuated Vaccine Design
Johanna M. Duyvestyn, Peter J. Bredenbeek, Marie J. Gruters, Ali Tas, Tessa Nelemans, Marjolein Kikkert, Martijn J. van Hemert
Overwintering of Usutu virus in mosquitoes, The Netherlands
C. J. M. Koenraadt, E. Münger, M. J. J. Schrama, J. Spitzen, S. Altundag, R. S. Sikkema, B. B. Oude Munnink, M. P. G. Koopmans & R. Blom
Springer Nature – Parasites & Vectors
Effects of immune status on stopover departure decisions are subordinate to those of condition, cloud cover and tailwind in autumn-migrating common blackbirds Turdus merula
Tjomme van Mastrigt, Kevin D. Matson, Sander Lagerveld, Xinrou S. Huang, Willem F. de Boer, Henk P. van der Jeugd
Future land use maps for the Netherlands based on the Dutch One Health Shared Socio-economic Pathways
Martha Dellar, Gertjan Geerling, Kasper Kok, Peter M. van Bodegom, Gerard van der Schrier, Maarten Schrama & Eline Boelee
Sentinel chicken surveillance reveals previously undetected circulation of West Nile virus in the Netherlands
Differential susceptibility of human motor neurons to infection with Usutu and West Nile virus
Eleanor M. Marshall, Lisa Bauer, Tessa Nelemans, Syriam Sooksawasdi Na Ayudhya, Feline Benavides, Kristina Lanko, Femke M. S. de Vrij, Steven A. Kushner, Marion Koopmans, Debby van Riel, Barry Rockx
Journal of Neuroinflammation BioMedCentral
Neurovirulence of Usutu virus in human fetal organotypic brain slice cultures partially resembles Zika and West Nile virus
Eleanor M. Marshall, Ahmad S. Rashidi, Michiel van Gent, Barry Rockx, Georges M. G. M. Verjans
Orthoflavivirus surveillance in the Netherlands: Insights from a serosurvey in horses & dogs and a questionnaire among horse owners
Kiki Streng, Renate W. Hakze-van der Honing, Heather Graham, Sophie van Oort, Pauline A. de Best, Ayat Abourashed, Wim H. M. van der Poel
Zoonoses and public health – Wiley online library
Taking it with a grain of salt: tolerance to increasing salinization in Culex pipiens (Diptera: Culicidae) across a low-lying delta
Sam Philip Boerlijst, Antje van der Gaast, Lisa Maria Wilhelmina Adema, Roderick Wiebe Bouman, Eline Boelee, Peter Michiel van Bodegom & Maarten Schrama
Landscape level associations between birds, mosquitoes and microclimates: possible consequences for disease transmission?
Blood-feeding patterns of Culex pipiens biotype pipiens and pipiens/molestus hybrids in relation to avian community composition in urban habitats
Distribution of Culex pipiens life stages across urban green and grey spaces in Leiden, The Netherlands
Louie Krol, Melissa Langezaal, Lisa Budidarma, Daan Wassenaar, Emilie A. Didaskalou, Krijn Trimbos, Martha Dellar, Peter M. van Bodegom, Gertjan W. Geerling & Maarten Schrama
Development and validation of the MosquitoWise survey to assess perceptions towards mosquitoes and mosquito-borne viruses in Europe
Ayat Abourashed, Pauline A. de Best, Laura Doornekamp, Reina S. Sikkema, Eric C. M. Van Gorp, Aura Timen, Frederic Bartumeus, John R. B. Palmer, Marion P.G. Koopmans
Creating the Dutch One Health Shared Socio-economic Pathways (SSPs)
Martha Dellar, Gertjan Geerling, Kasper Kok, Peter van Bodegom, Maarten Schrama & Eline Boelee
A species-independent lateral flow microarray immunoassay to detect WNV and USUV NS1-specific antibodies in serum
Bijan Godarzi, Felicity Chandler, Anne van der Linden, Reina S. Sikkema, Erwin de Bruin, Edwin Veldhuizen, Aart van Amerongen, Andrea Gröne.
Fish as food source for nestlings in Common blackbirds
The potential of resilience indicators to anticipate infectious disease outbreaks, a systematic review and guide
Clara Delecroix, Egbert H. van Nes, Ingrid A. van de Leemput, Ronny Rotbarth, Marten Scheffer, Quirine ten Bosch
The increasing complexity of arbovirus serology: An in-depth systematic review on cross-reactivity
Louella M. R. Kasbergen , David F. Nieuwenhuijse, Erwin de Bruin, Reina S. Sikkema, Marion P. G. Koopmans
PLOS Neglected Tropical Diseases
Interactive effects of climate, land use and soil type on Culex pipiens/torrentium abundance
Louie Krol, Rody Blom, Martha Dellar, Jordy G. van der Beek, Arjan C.J. Stroo, Peter M. van Bodegom, Gertjan W. Geerling, Constantianus J.M. Koenraad, Maarten Schrama.
Competition between two Usutu virus isolates in cell culture and in the common house mosquito Culex pipiens
Joyce W. M. van Bree, Charlotte Linthout, Teije van Dijk, Sandra R. Abbo, Jelke J. Fros, Constantianus J. M. Koenraadt, Gorben P. Pijlman and Haidong Wang
The pathology of co-infection with Usutu virus and Plasmodium spp. in naturally infected Eurasian blackbirds (Turdus merula)
Gianfilippo Agliani, Giuseppe Giglia, Erwin de Bruin, Tjomme van Mastrigt, Rody Blom, Reina S. Sikkema, Marja Kik, Marion P.G. Koopmans, Andrea Gröne, Judith M.A. Van den Brand.
Assessing West Nile virus (WNV) and Usutu virus (USUV) exposure in bird ringers in the Netherlands: a high-risk group for WNV and USUV infection?
Chiara de Bellegarde de Saint Lary, Louella M.R. Kasbergen, Patricia C.J.L. Bruijning-Verhagen, Henk van der Jeugd, Felicity Chandler, Boris M. Hogema, Hans L. Zaaijer, Fiona R.M. van der Klis, Luisa Barzon, Erwin de Bruin, Quirine ten Bosch, Marion P.G. Koopmans, Reina S. Sikkema, Leo G. Visser
Composition and global distribution of the mosquito virome – A comprehensive database of insect-specific viruses
Jurgen P. Moonen, Michelle Schinkel, Tom van der Most, Pascal Miesen, Ronald P. van Rij
Arbovirus persistence in North-Western Europe: Are mosquitoes the only overwintering pathway?
Rody Blom, Maarten J.J.Schrama, Jeroen Spitzen, Babette F.M.Weller, Annevan der Linden, Reina S.Sikkema, Marion P.G. Koopmans, Constantianus J.M. Koenraadt
Anopheles maculipennis Complex in The Netherlands: First Record of Anopheles daciae (Diptera: Culicidae)
A. Ibáñez-Justicia, Nathalie Smitz, Rody Blom, Ann Vanderheyden, Frans Jacobs, Kenny Meganck, Sophie Gombeer, Thierry Backeljau, Constantianus J. M. Koenraadt, J. S. Griep, Marc De Meyer, Arjan Stroo
MDPI
Anopheles maculipennis Complex in The Netherlands: First Record of Anopheles daciae (Diptera: Culicidae)
Improving estimations of life history parameters of small animals in mesocosm experiments: A case study on mosquitoes
M. Dellar, S. P. Boerlijst, D. Holmes
Methods in Ecology and Evolution
State-dependent environmental sensitivity of reproductive success and survival in a shorebird
Jurrian van Irsel* (Corresponding author), Magali Frauendorf, Bruno J. Ens, Martijn van de Pol, Karin Troost, Kees Oosterbeek, Hans de Kroon, Eelke Jongejans, Andrew M. Allen
Emerging arboviral diseases
P. de Best*, M. de Wit*, K. Streng*, M. Dellar, M. Koopmans
Nederlands Tijdschrift voor Medische Microbiologie
The Potential Role of School Citizen Science Programs in Infectious Disease Surveillance: A Critical Review
A. Abourashed, L. Doornekamp , S. Escartin , C. J. M. Koenraadt, M. Schrama , M. Wagener, F. Bartumeus , E.C. M. van Gorp
International Journal of Environmental Research and Public Health
Pathology and Pathogenesis of Eurasian Blackbirds (Turdus merula) Naturally Infected with Usutu Virus
G. Giglia, G. Agliani, B. Oude Munnink, R. S. Sikkema, M. Mandara, E. Lepri, M. Kik, J. Ijzer, J. M. Rijks, C. Fast, M. P. G. Koopmans, M. H. Verheije, A.Gröne, C.B. E. M. Reusken, and J. M. A. van den Brand
Journal: Viruses
Genetic determinants of antiviral immunity in dipteran insects – Compiling the experimental evidence
S. R. Machado, T. van der Most, P. Miesen
Developmental & Comparative Immunology
Detection of West Nile virus in a common whitethroat (Curruca communis) and Culex mosquitoes in the Netherlands, 2020
R. S. Sikkema , M. Schrama , T. van den Berg , J. Morren , E. Munger , L. Krol, J. G. van der Beek, R. Blom, I. Chestakova, A. van der Linden , M. Boter, T. van Mastrigt, R. Molenkamp, C. J. M. Koenraadt, J. M. A. van den Brand, B. B. Oude Munnink, M. P. G. Koopmans, H. van der Jeugd
Eurosurveillance